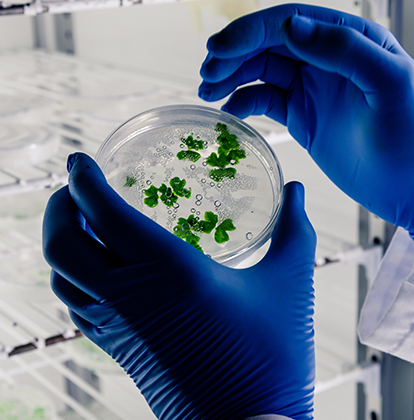
image

-
Apply For Courses

-
Law
 LawCommerce
LawCommerce CommerceParamedical
CommerceParamedical ParamedicalArts/Humanities
ParamedicalArts/Humanities Arts/HumanitiesManagement
Arts/HumanitiesManagement

Applied Physics (M.Sc)

Applied Chemistry(M.Sc)

Applied Mathematics (M.Sc)
Biotechnology (M.Sc)

Environmental Science (M.Sc)
Welcome! Sign up or Login
Welcome! Sign up or Login
Welcome! Sign up or Login
OTP Verification
OTP Verification
Enter the verification code recieved on your Email ID.(Note: Check Spam also.)
00:30
OTP Verification
Enter the verification code recieved on your Email ID.(Note: Check Spam also.)
00:30
Do you like cookies? We use cookies to ensure you get the best experience on our website.
Learn more
